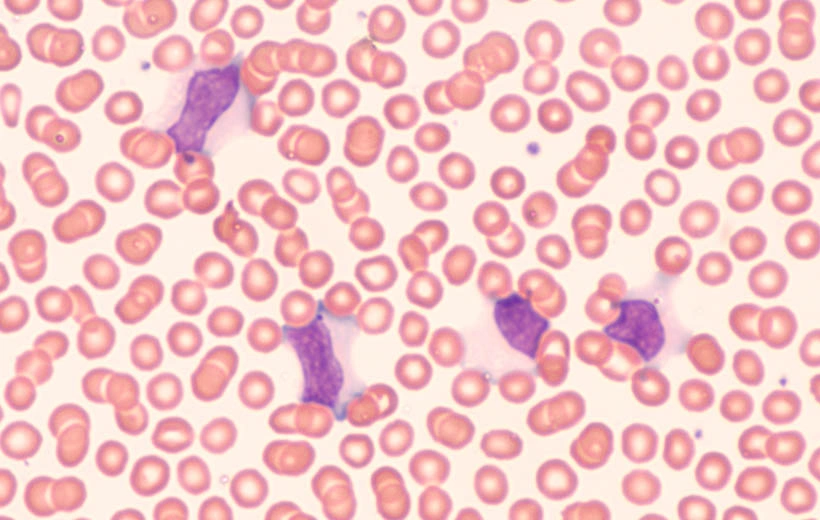
Вирус Эпштейна &ndash; Барр: симптомы, диагностика, лечение

Вирус Эпштейна – Барр (ВЭБ) относится к герпесвирусам 4-го типа. Попадая в организм человека, паразитирует в нем пожизненно.
Назван по фамилиям английских вирусологов, которые описали его в 1964 году (Майкл Эпштейн и Ивонна Барр).
До сих пор остается самым загадочным из всех возбудителей, и не каждый врач сможет объяснить, что это такое, вирус Эпштейна – Барр, и к каким изменениям в организме он приводит.
Особенности возбудителя
Герпесвирус 4-го типа содержит ДНК. Его присутствие в организме сопровождается пролиферацией клеток. Он способен вызывать изменение (мутацию) генетического клеточного кода, что приводит к появлению атипичных клеток, развитию онкологии.
Первичное размножение происходит в лимфоидной ткани миндалин, затем кровотоком и по лимфатическим путям распространяется по всему организму.
Причины возникновения вируса Эпштейна – Барр
Вирус Эпштейна – Барр присутствует у большинства людей. Но заболевания развиваются лишь у небольшого числа инфицированных.
Заражение происходит в большинстве случаев в детском и подростковом возрасте.
Вирус Эпштейна – Барр относится к возбудителям, которые не распространяются по воздуху, как вирус гриппа.
Передается при тесном контакте через слюну или слизистые выделения из носа и глотки. Это наиболее частый путь распространения данного микроорганизма.
Заражение происходит через поцелуи, плохо вымытую посуду, при недостаточном соблюдении правил личной гигиены.
Кроме того, вирус Эпштейна – Барр передается такими путями, как:
- контактно-бытовой и половой;
- гемотрансфузионный (при переливании крови);
- трансплацентарный (от матери плоду).
Причинами, провоцирующими заражение и размножение вируса Эпштейна – Барр, являются:
- понижение активности противовирусного иммунитета;
- присутствие острого воспалительного процесса, вызванного бактериями или другими вирусами;
- недавнее проведение вакцинации;
- стрессовые ситуации;
- ВИЧ-инфекция;
- гиповитаминоз.
Присутствие вируса в организме приводит к выработке специфических антител, иммуноглобулинов классов М и G.
М-антитела вырабатываются сразу после заражения, а G- синтезируются позже и сохраняются пожизненно.
Наличие специфических антител – это не иммунитет, как при других инфекциях, а свидетельство присутствия ВЭБ в организме.
Заболевания, вызываемые вирусом Эпштейна – Барр
Первичный контакт организма с вирусом бывает в виде:
- инфекционного мононуклеоза, обычно у подростков и молодых людей;
- бессимптомного инфицирования или по типу ОРВИ у детей.
Хроническая инфекция может быть в виде:
- бессимптомного течения, без явных признаков болезни;
- активно протекающего хронического рецидивирующего мононуклеоза;
- генерализованного поражения внутренних органов и нервной системы;
- гемофагоцитарного синдрома, при котором развиваются анемия и тромбоцитопения;
- стертого варианта течения, с атипичной симптоматикой, под маской другого воспалительного процесса;
- онкологии, чаще всего лимфоидной ткани (множественные лимфомы с различной локализацией);
- системного, аутоиммунного заболевания, в том числе системной красной волчанки или ревматоидного артрита;
- синдрома хронической усталости.
Симптомы заболеваний, обусловленных вирусом Эпштейна – Барр
Симптоматика определяется формой болезни.
Проявления инфекционного мононуклеоза первой, острой стадии, возникшего при попадании в организм вируса Эпштейна – Барр, не отличаются у детей и взрослых.
Клиническая картина складывается из симптомов общей интоксикации, характерных изменений в общем анализе крови, плотных увеличенных лимфоузлов, воспаления лимфоидной ткани в глотке.
Признаки мононуклеоза при вирусе Эпштейна – Барр:
- Высокая температура. Лихорадка сохраняется длительно, температура повышается до 39–40 °С.
- Умеренная болезненность во время глотания, при интенсивных наложениях на миндалинах и выраженной отечности слизистой глотки.
- Затруднение носового дыхания, гнусавость голоса, храп во время сна.
- Увеличение всех групп лимфатических узлов, но в большей степени расположенных на шее.
- Увеличение печени и большая селезенка.
Не всегда, но могут быть кожные высыпания, при тяжелом течении – желтушность кожных покровов и видимых слизистых оболочек.
Хронические варианты инфекции, обусловленной вирусом Эпштейна – Барр, у мужчин и женщин протекают одинаково.
Характерными признаками бывают:
- При активной рецидивирующей форме больных беспокоят слабость, небольшая температура, лимфаденопатия, болезненность в горле. Могут быть сыпь на коже, нарушения сна, головные боли, ломота в теле. Часто присоединяются другие бактериальные и вирусные воспаления, такие как простой герпес, хронический тонзиллит, грибковые поражения. Бывают эмоциональная нестабильность, плохой прерывистый сон.
- Генерализованная форма обычно развивается при иммунодефиците, свойственна больным с ВИЧ. Вирус поражает внутренние органы (развиваются миокардит, пневмония, тяжелый гепатит, нефрит), нервную систему (менингит, энцефалит).
- Для гемофагоцитарного синдрома характерно снижение уровня гемоглобина, тромбоцитов, геморрагические проявления. У больных отмечаются лихорадка с суточными колебаниями температуры до двух градусов, нарушения в работе печени.
- Стертые варианты бывают двух типов течения. Первый с длительной субфебрильной температурой и второй с наличием частых воспалительных процессов в респираторном тракте, кишечнике, коже, мочевыводящих путях или половых органах.
Диагностика заболеваний, вызванных вирусом Эпштейна – Барр
Для подтверждения наличия ВЭБ проводятся лабораторные и инструментальные исследования.
В анализах при инфицировании вирусом Эпштейна – Барр определяются:
- в периферической крови лимфоцитоз и атипичные мононуклеары (слишком молодые лейкоциты);
- в биохимии высокий уровень печеночных ферментов;
- по УЗИ расширение границ печени и селезенки.
При хронических вариантах и разной активности течения выявляется увеличение количества лимфоцитов (реже моноцитов) и иногда присутствуют атипичные мононуклеары.
ВЭБ находят в крови и других биологических жидкостях при ПЦР-исследовании.
Подтверждается ВЭБ-инфекция наличием специфических антител, выявляемых методом ИФА.
На разных стадиях болезни:
- М-антитела при первичном инфицировании, реже при активации процесса;
- G-антитела к раннему вирусному антигену при недавнем заражении или при активном течении болезни;
- G-антитела к ядерному антигену, когда возбудитель попал в организм давно.
Судить о давности болезни можно по авидности антител. Это тест прочности связи специфических антигенов с антителами. Низкая авидность бывает при недавнем заболевании, а высокая свидетельствует о длительном присутствии вируса.
Лечение вируса Эпштейна – Барр
Эффективных схем, принятых врачами и учеными во всем мире, нет.
Препараты, действующие на вирус Эпштейна – Барр и вызывающие его гибель или выведение из организма, не разработаны.
Используются средства, способствующие синтезу собственных интерферонов и повышающие активность неспецифических противовирусных сил организма.
В случае тяжелого течения болезни возможно применение готовых интерферонов и иммуноглобулинов, блокирующих находящиеся в крови вирусы.
Препаратами, помогающими справиться с воспалением, являются глюкокортикостероиды и нестероидные противовоспалительные средства.
Проводится патогенетическая и симптоматическая терапия, помогающая больному преодолеть вредное воздействие размножающихся вирусов.
Успех в лечении зависит от правильного режима и полноценного диетического питания.
Профилактика вируса Эпштейна – Барр
Специфическая профилактика отсутствует, вакцины нет.
Меры по ограничению распространения вируса направлены на изоляцию пациента при острой стадии болезни.
Учитывая особенности ВЭБ, наличие как тяжелых форм болезни, так и бессимптомного носительства, важно не создавать благоприятных условий для его развития.
Поэтому профилактическими мерами против ВЭБ можно считать:
- здоровый, правильный образ жизни, достаточный сон и высокую физическую активность;
- полноценное питание, содержащее необходимое количество витаминов, минералов и других биологически активных веществ;
- профилактические меры против инфицирования ВИЧ и вирусными гепатитами.
Полностью исключить попадание в организм ВЭБ не удастся, но уменьшить его активность возможно.